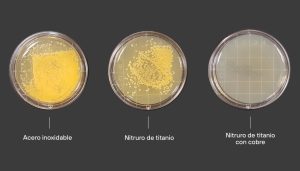

Superficies metálicas antivirales. Es difícil predecir dónde o cuándo emergerán nuevas epidemias. Pero lo que es seguro es que, con el cambio climático y la globalización, nuevas amenazas infecciosas seguirán apareciendo y propagándose.
La OMS cada cierto tiempo reúne a científicos y expertos en salud pública para establecer una lista de los patógenos emergentes susceptibles de causar la próxima pandemia.
Patógenos emergentes a causar epidemias
En el 2016 se llevó a cabo una de estas sesiones, en ella se determinó que la lista se constituye por virus de los que relativamente se conoce poco y para los cuales no existen vacunas ni tratamiento.
Dentro de esta lista podemos encontrar a virus como la fiebre de Lassa, Enfermedad del Ébola, el Mers (Síndrome Respiratorio de Oriente Medio), el Chikunguña, el ZIKA y el SARS (Síndrome Respiratorio Agudo Grave).
Este último ha tenido una mutación que nos está afectando gravemente en diferentes sectores, reportándose hasta ahora aproximadamente 534,000 muertes en el mundo.
Por lo que es de suma importancia estar preparados para las siguientes posibles nuevas epidemias que se llegasen a presentar. El objetivo principal es reducir la tasa de contagio.
Por lo que se han desarrollado varias tecnologías con materiales antivirales, que maten diversos virus en el menor tiempo posible y usarlos en piezas de la vida cotidiana.
Tecnologías antivirales en superficies metálicas
Superficies metálicas antivirales. El centro de investigación Tekniker ha desarrollado recubrimientos mediante Physical Vapour Deposition (PVD). Que permite depositar capas metálicas, nitruros, óxidos y otros compuestos mediante la evaporación en vacío de distintos materiales sobre substratos metálicos.
Dichos recubrimientos son de nitruros de titanio y de tántalo dopados con cobre para fabricar superficies que destruyen los patógenos.
Se compararon diferentes metales: acero inoxidable, nitruro de titanio y nitruro de titanio dopado con cobre, la prueba antibactericida se hizo con S. Aureus. Es una bacteria altamente infecciosa que se encuentra comúnmente en la nariz, causa infecciones en la piel, neumonía, infecciones de las válvulas cardíacas e infecciones óseas.
Superficies metálicas antivirales. En la superficie de acero inoxidable, comúnmente empleado en la industria alimentaria, se encontró una gran cantidad de colonias bacterianas. Siendo el recubrimiento con mayor proliferación de bacterias, seguido del recubrimiento de nitruro de titanio. Mientras que el recubrimiento de nitruro de titanio dopado con cobre, no proliferaron las colonias bacterianas.
Recubrimientos Sol-gel
Además del PVD, se realizaron recubrimientos basados en matrices de Sol-Gel con óxido de silicio y óxido de titanio con nanopartículas metálicas.
Que funcionan como agentes antibacterianos, eliminan compuestos orgánicos por la acción de los rayos ultravioleta (UV).
Esta tecnología se puede aplicar mediante spray por lo que tienen gran potencial de aplicación en muchos tipos de productos.
Mediante electro oxidación por plasma, técnica utilizada para crear capas de óxido de alta dureza y propiedades de protección a la corrosión.
Se realizó un recubrimiento óxidos de titanio dopados con distintos iones. Proporcionando una reducción en el crecimiento bacteriano, este trabajo se empleó posteriormente para implantes.
Tecnología con láser
En tecnologías como láser pulsado se han desarrollado diferentes microestructuras sobre superficies metálicas que tienen propiedades de hidrofobicidad. Repelen el agua, previenen el depósito de bacterias y tienen tasas de mortalidad de hasta un 90%.
Estos recubrimientos se han empleado en aleaciones de titanio, aluminio, acero y de materiales poliméricos como polipropileno.
Este tipo de tecnologías serán las pioneras en desarrollar los recubrimientos metálicos del futuro, puesto que, ademàs de poseer alta dureza y poder anticorrosivo, tendrán cualidades antivirales.
La tasa de contagio provocada por algunos virus, se verá afectada positivamente, disminuyendo el contagio por superficies infectadas.



